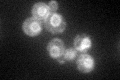
YGL012W
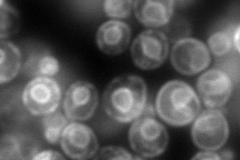
YGL012W

View description
C-24(28) sterol reductase, catalyzes the final step in ergosterol biosynthesis; mutants are viable, but lack ergosterol
Localization:
Intensity:
Fold change:
Significance:
-
C’ GFP library in SD
ER60.37 -
N' NOP1pr-GFP in SD

ER201.962 -
N' TEF2pr-mCherry in SD
ER302.622 -
N' NATIVEpr-GFP in SD

ER57.0539 -
N' TEF2pr-VC and Cyto-VN in SD

ER50.7305 -
C’ GFP library in SD+DTT

ER44.070.72No -
C’ GFP library in SD+H2O2

ER36.060.59Yes -
C’ GFP library in Starvation Media

ER23.820.39Yes -
C’ GFP library on the background of Pup2-DaMP

ER -
C’ GFP library on the background of CCT mutant

ER40.08420.663862Yes
